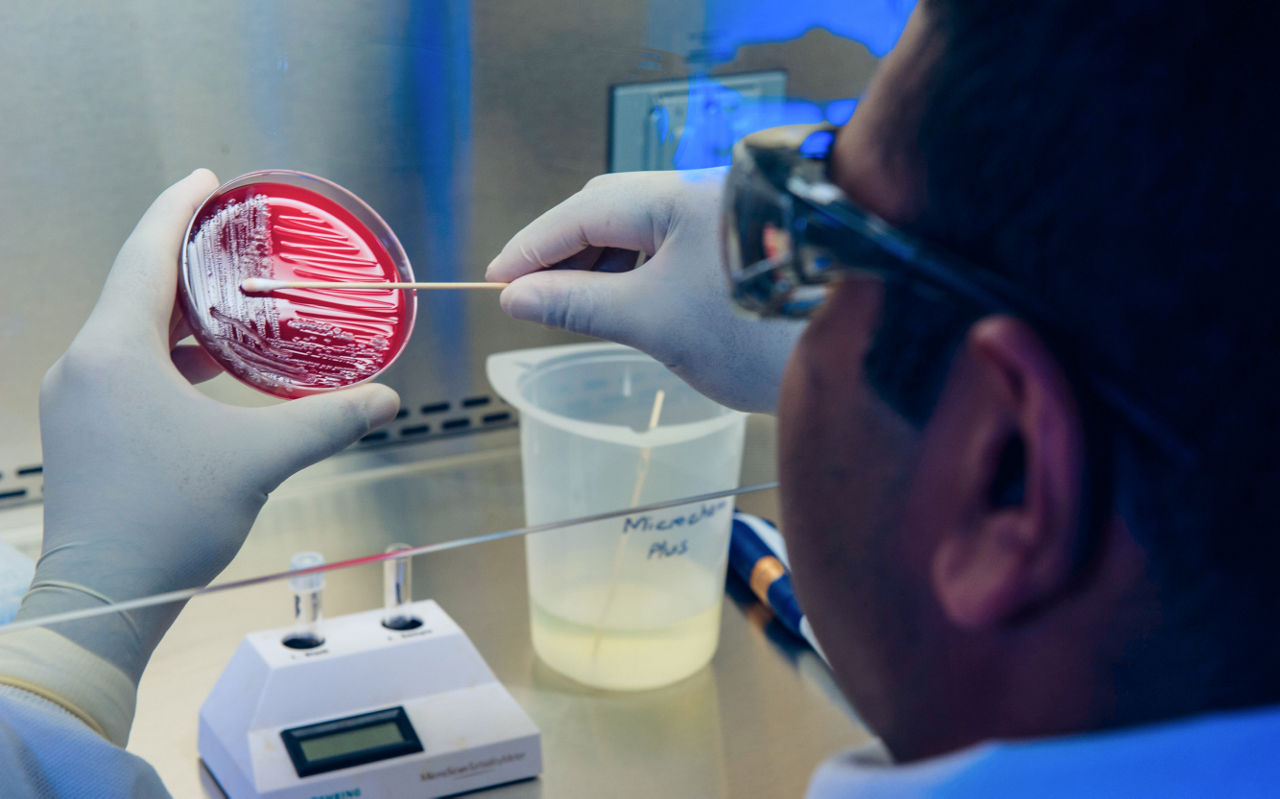
scientist swabbing a petri dish

Taconic Biosciences is the only comprehensive provider of microbiome product and service solutions, a world leader in germ-free husbandry, and has produced germ-free rodent models since 1961.
Germ-Free Mice

Taconic offers several standard mouse strains as off-the-shelf germ-free mice for immediate delivery in typical study sizes, along with a specialized germ-free GEM model for colitis research. Germ-free mice are devoid of all microorganisms (as determined within the limitations of the detection methods available), including bacteria, fungi and viruses; they have no microbiome. Strict Taconic husbandry and testing programs ensure that these mice remain germ-free; to assure preservation of the Germ-Free health standard of your animals during shipping, Taconic has designed and constructed a unique container system, the germ-free shipper.
“Seres relies on Taconic's germ-free mice to study the microbiome and our drug candidates.”
– Seres Therapeutics
“Federation Bio utilizes Taconic's germ-free mouse models to advance our pre-clinical research programs. As an early stage microbiome biotech company, Taconic has been a valuable partner in our pre-clinical research.”
– Federation Bio
Germ-free mice may be maintained as germ-free long-term or they may be associated with a custom microbiota. Taconic provides custom association services using customer-provided materials.
Taconic's inbred C57BL/6NTac, BALB/cAnNTac, outbred Swiss Webster and genetically engineered Il10 Knockout (B6) mice are immediately available from our commercial production colonies at the Germ-Free (GF) health standard.
- Germ Free C57BL/6 (Black 6)
- Germ Free BALB/c
- Germ Free Swiss Webster
- Germ Free Il10 Knockout (B6)
Germ Free C57BL/6 (Black 6)
Strain Snapshot:
- C57BL/6, also called Black 6 or B6, is the most commonly used inbred strain. It is the preferred background strain for most genetically engineered mouse models.
- B6 is a versatile mouse strain. It is the preferred strain for diet-induced obesity studies. It is used in a number of autoimmune disease models, including experimental autoimmune encephalomyelitis (EAE) and the collagen-induced arthritis (CIA) model. For oncology, B6 has been used in syngeneic tumor models. It is also used in addiction, behavior, toxicology and many other research areas.
- The Taconic B6, C57BL/6NTac, is the substrain from which most B6 embryonic stem (ES) cells have been derived. The KOMP and MPC programs use C57BL/6NTac-derived ES cells.
- Immunology: Th1-biased
- More information and pricing is available on the Black 6 page.
Availability: Germ Free Black 6 mice are available for immediate delivery. Study cohorts available of 100+.
Germ Free BALB/c
Taconic is the only commercial provider of germ-free BALB/c mice.
Strain Snapshot:
- BALB/c is a commonly used, general purpose inbred strain with good reproductive performance.
- BALB/c is widely used for immunology studies. It displays good antibody production and is often used for vaccine studies and production of monoclonal antibodies. BALB/c is widely used for syngeneic tumor model studies as well as in asthma and allergy studies.
- Immunology: Th2-biased
- More information and pricing is available on the BALB/c page.
Availability: Germ Free BALB/c mice are available in small cohort quantities.
Germ Free Swiss Webster
Taconic is the only commercial provider of germ-free Swiss Webster mice.
Strain Snapshot:
- Swiss Webster is a general purpose outbred strain with excellent reproductive performance.
- Extensively used for decades as an all-purpose stock for research and drug safety testing. Swiss Webster is also commonly used for gnotobiotic support. GF Swiss Webster mice are excellent embryo recipients or foster mothers.
- More information and pricing is available on the Swiss Webster page.
Availability: Germ Free Swiss Webster mice are available for immediate delivery. Study cohorts available of 50+.
Germ Free Il10 Knockout (B6)
Taconic is the only commercial provider of germ-free Il10 Knockout mice.
Strain Snapshot:
- Il10 Knockout mice are useful for studying colitis and immunoregulatory pathways.
- Colitis severity and onset are expected to vary by genetic background in Il10 knockouts, with reported earlier onset and greater severity in BALB/c vs. C57BL/6 backgrounds (J Clin Invest. 1996 Aug 15;98(4):1010-20).
- Taconic offers the Il10 Knockout on the C57BL/6 background at Germ-Free and the Il10 Knockout on the BALB/c background at the Opportunist Free (conventional microbiome)
- Although germ-free Il10 knockouts do not develop colitis (Infect Immun. 1998 Nov;66(11):5224-31), the introduction of select microbes or fecal microbiomes may induce rapid colitis onset in adult animals (Inflamm Bowel Dis. 2007 Dec;13(12):1457-66).
- More information and pricing is available on the C57BL/6 Il10 Knockout (B6) and Il10 Knockout (BALB/c) pages.
Availability: C57BL/6 Germ-Free Il10 Knockout (B6) mice are available for immediate delivery. Study cohorts available of 30+. Orders for males may require additional lead time.
Watch the following Taconic video "Flexible Film Isolator Demonstration" to see a detailed demonstration on how to work with a germ-free isolator and pack a germ-free shipper. Step-by-step unpacking instructions for the germ-free shipper can be found on our animal shipping products page.
Featured Resources
Get In Touch
Book a complimentary consultation or get support for an existing order
If you need immediate assistance, please contact Customer Service:
Taconic Corporate Offices
Email: info@taconic.com
Phone: +1 (518) 697-3900
273 Hover Ave., Germantown, NY 12526
North American Customer Service
Email: info@taconic.com
Phone: +1 (518) 697-3915
Toll-free: +1 (888) 822-6642
Hours: (Monday - Friday): 7 a.m. - 6 p.m. ET
European Customer Service
Email: info@taconic.com
Phone (Europe and Denmark): +45 70 23 04 05
Phone (Germany): +49 214 50 68 023
Hours: (Monday - Friday): 7 a.m. - 5 p.m. CET

















.jpg)

.jpg)
.jpg)
.jpg)
.jpg)





.jpg)


.jpg)
.jpg)




.jpg)





.jpg)

.jpg)